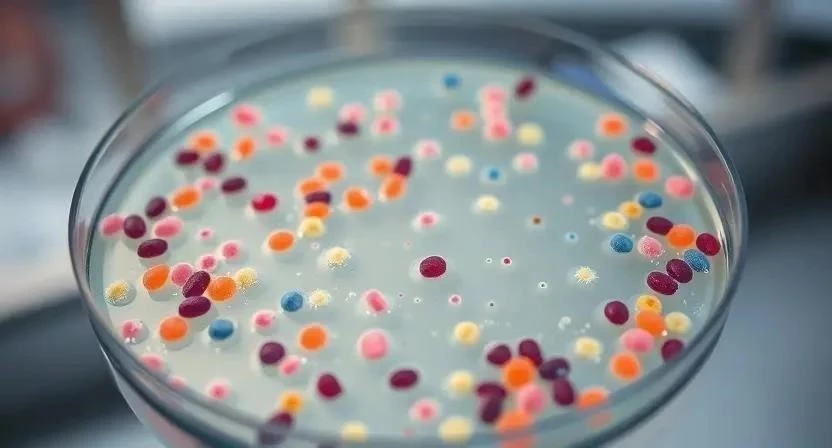

Задумывались ли вы когда-нибудь, насколько часто мы сталкиваемся с бактериями? Они окружают нас повсюду, и большинство из них безвредны, а некоторые даже полезны. Но когда бактерии становятся патогенными, они могут вызывать серьезные инфекции. По статистике, бактериальные инфекции являются одной из основных причин заболеваемости и смертности во всем мире. Ключевое слово – бактериальные инфекции. Важно понимать, как защитить себя и своих близких от этой угрозы.
- Что такое бактериальные инфекции: Определение‚ виды бактерий‚ механизмы заражения
- Наиболее распространенные бактериальные инфекции
- Симптомы бактериальных инфекций: Общие и специфические признаки‚ как распознать инфекцию
- Диагностика бактериальных инфекций: Лабораторные методы (анализы крови‚ мочи‚ посевы)‚ инструментальные методы (рентген‚ КТ)
- Лечение бактериальных инфекций
- Устойчивость к антибиотикам: Причины‚ последствия‚ пути решения проблемы
- Профилактика бактериальных инфекций
- Бактериальные инфекции и система здравоохранения: Нагрузка на больницы‚ экономические затраты‚ меры по контролю инфекций
- FAQ: Ответы на часто задаваемые вопросы
Что такое бактериальные инфекции: Определение‚ виды бактерий‚ механизмы заражения
Бактериальные инфекции – это заболевания, вызываемые размножением патогенных бактерий в организме человека. Бактерии – это микроскопические одноклеточные организмы, которые могут обитать в различных средах, включая почву, воду и тело человека. Существуют тысячи видов бактерий, но лишь некоторые из них способны вызывать заболевания. Механизмы заражения разнообразны: воздушно-капельный путь, контактный путь, через загрязненную пищу или воду, а также через раны и порезы.
Наиболее распространенные бактериальные инфекции
К сожалению, бактериальные инфекции могут поражать различные органы и системы организма. Вот некоторые из наиболее распространенных:
- Инфекции верхних дыхательных путей (стрептококк, стафилококк): ангина, фарингит, тонзиллит.
- Инфекции нижних дыхательных путей (пневмония): воспаление легких, бронхит.
- Инфекции мочевыводящих путей: цистит, пиелонефрит.
- Кишечные инфекции (сальмонеллез, дизентерия): диарея, рвота, боли в животе.
- Кожные инфекции (фурункулы, карбункулы): гнойные воспаления кожи.
- Менингит: воспаление оболочек головного и спинного мозга.
- Сепсис: генерализованная инфекция, характеризующаяся системным воспалительным ответом.
Симптомы бактериальных инфекций: Общие и специфические признаки‚ как распознать инфекцию
Симптомы бактериальных инфекций могут варьироваться в зависимости от типа инфекции и тяжести заболевания. Общие признаки включают лихорадку, слабость, усталость, головную боль и потерю аппетита. Специфические симптомы зависят от пораженного органа или системы. Например, при пневмонии наблюдается кашель с мокротой, одышка и боль в груди, а при кишечной инфекции – диарея, рвота и боли в животе. Важно не заниматься самолечением и обратиться к врачу при появлении подозрительных симптомов.

Диагностика бактериальных инфекций: Лабораторные методы (анализы крови‚ мочи‚ посевы)‚ инструментальные методы (рентген‚ КТ)
Для диагностики бактериальных инфекций используются различные лабораторные и инструментальные методы. Лабораторные методы включают анализ крови, мочи и других биологических жидкостей для выявления бактерий или признаков воспаления. Посевы позволяют идентифицировать конкретный вид бактерии и определить ее чувствительность к антибиотикам. Инструментальные методы, такие как рентген и КТ, помогают оценить состояние пораженных органов и тканей.
Лечение бактериальных инфекций
Лечение бактериальных инфекций зависит от типа инфекции, ее тяжести и чувствительности бактерий к антибиотикам.
- Антибиотики: являются основным средством лечения бактериальных инфекций. Они действуют, подавляя рост и размножение бактерий. Важно помнить, что антибиотики эффективны только против бактерий и не действуют на вирусы.
- Альтернативные методы лечения: в некоторых случаях, особенно при легких инфекциях, можно использовать симптоматическое лечение, такое как жаропонижающие и обезболивающие препараты. Иммуномодуляторы могут помочь укрепить иммунную систему и ускорить выздоровление.
- Важность соблюдения режима лечения: очень важно строго соблюдать режим лечения, назначенный врачом, и принимать антибиотики в течение всего курса, даже если симптомы исчезли. Преждевременное прекращение лечения может привести к развитию устойчивости бактерий к антибиотикам.
Устойчивость к антибиотикам: Причины‚ последствия‚ пути решения проблемы
Устойчивость к антибиотикам – это серьезная проблема общественного здравоохранения, которая возникает, когда бактерии становятся устойчивыми к действию антибиотиков. Причины устойчивости к антибиотикам включают чрезмерное и неправильное использование антибиотиков, а также естественную способность бактерий к адаптации и мутациям. Последствия устойчивости к антибиотикам могут быть катастрофическими, так как инфекции становятся труднее поддаваться лечению, что приводит к увеличению заболеваемости и смертности. Пути решения проблемы включают рациональное использование антибиотиков, разработку новых антибиотиков и улучшение мер по контролю инфекций.
Профилактика бактериальных инфекций
Профилактика бактериальных инфекций – это лучший способ защитить себя и своих близких от этих заболеваний.
- Гигиена (мытье рук, дезинфекция): регулярное мытье рук с мылом и дезинфекция поверхностей помогают уничтожить бактерии и предотвратить их распространение.
- Вакцинация: вакцинация является эффективным способом защиты от некоторых бактериальных инфекций, таких как пневмококковая инфекция и менингит.
- Здоровый образ жизни (правильное питание, физическая активность): здоровый образ жизни укрепляет иммунную систему и повышает устойчивость организма к инфекциям.
- Избегание контакта с больными людьми: избегайте тесного контакта с людьми, страдающими бактериальными инфекциями, чтобы снизить риск заражения.
Бактериальные инфекции и система здравоохранения: Нагрузка на больницы‚ экономические затраты‚ меры по контролю инфекций
Бактериальные инфекции оказывают значительное влияние на систему здравоохранения. Они являются причиной большого количества госпитализаций, увеличивают нагрузку на больницы и приводят к значительным экономическим затратам. Меры по контролю инфекций, такие как изоляция больных, дезинфекция помещений и использование средств индивидуальной защиты, помогают снизить распространение инфекций в больницах и других медицинских учреждениях.
FAQ: Ответы на часто задаваемые вопросы
Вопрос: Что делать, если я подозреваю у себя бактериальную инфекцию?
Ответ: Обратитесь к врачу для диагностики и назначения лечения.
Вопрос: Можно ли лечить бактериальную инфекцию самостоятельно?
Ответ: Самолечение может быть опасным и привести к развитию устойчивости бактерий к антибиотикам. Всегда консультируйтесь с врачом.
Вопрос: Как предотвратить распространение бактериальных инфекций?
Ответ: Соблюдайте правила гигиены, вакцинируйтесь и избегайте контакта с больными людьми.
Таблица 1: Симптомы и виды бактериальных инфекций
| Инфекция | Симптомы |
|---|---|
| Пневмония | Кашель, одышка, лихорадка, боль в груди |
| Кишечная инфекция | Диарея, рвота, боли в животе, лихорадка |
| Инфекция мочевыводящих путей | Частое мочеиспускание, боль при мочеиспускании, лихорадка |
| Менингит | Головная боль, ригидность затылочных мышц, лихорадка, тошнота |
Таблица 2: Антибиотики и их применение
| Антибиотик | Применение | Побочные эффекты |
|---|---|---|
| Пенициллин | Инфекции верхних дыхательных путей, кожные инфекции | Аллергические реакции, диарея |
| Азитромицин | Инфекции нижних дыхательных путей, кишечные инфекции | Тошнота, рвота, диарея |
| Ципрофлоксацин | Инфекции мочевыводящих путей, сепсис | Головная боль, головокружение, тошнота |
Таблица 3: Меры профилактики бактериальных инфекций
| Мера профилактики | Описание |
|---|---|
| Мытье рук | Регулярное мытье рук с мылом в течение 20 секунд |
| Вакцинация | Вакцинация против пневмококковой инфекции и других бактериальных инфекций |
| Дезинфекция | Дезинфекция поверхностей, с которыми часто контактируют люди |
Таблица 4: Сравнение методов диагностики
| Метод диагностики | Преимущества | Недостатки |
|---|---|---|
| Анализ крови | Быстрый и простой | Не всегда точный |
| Анализ мочи | Позволяет выявить инфекции мочевыводящих путей | Не подходит для диагностики других инфекций |
| Посев | Позволяет идентифицировать конкретный вид бактерии | Требует времени |







